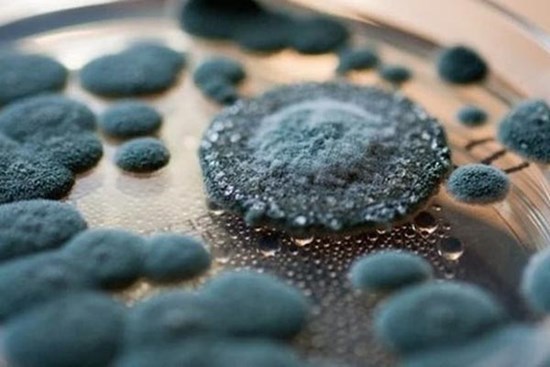

Chủ đề
nhiễm nấm
Tự ý điều trị ngứa, nam thanh niên bị nấm mọc toàn thân
Sau khi tự điều trị mẩn ngứa bằng loại thuốc bôi mua trên mạng không rõ nhãn mác, nam thanh niên ngứa toàn thân, đến viện khám được chẩn đoán nhiễm nấm da toàn thân.
Khoang miệng người phụ nữ “nở hoa” trắng xóa, đau đớn vì nhiễm loại nấm tưởng chỉ có ở vùng kín
Nhắc đến nấm Candida, nhiều người cho rằng nó chỉ tấn công vùng kín. Nhưng trong một số trường hợp, nó có thể xuất hiện ở vài bộ phận khác.
3 loại nấm mốc có thể xuất hiện trong nhà khiến bạn mắc bệnh
Nhiều người nghĩ rằng nấm mốc chỉ xuất hiện ở những ngôi nhà cũ, nhưng thực tế, bất kỳ ngôi nhà nào cũng có thể bị nấm mốc do nhiều nguyên nhân.
WHO công bố danh sách nóng về mối đe dọa sức khỏe toàn cầu mới
Tổ chức Y tế thế giới (WHO) vừa công bố danh sách đầu tiên về các loại nấm gây ra mối đe dọa lớn nhất đối với sức khỏe con người, bao gồm loại nấm đen Mucormycosic được bàn đến nhiều ở Việt Nam sau giai đoạn cao điểm của dịch COVID-19.
Bệnh nấm đen nguy hiểm thế nào?
Nấm đen là bệnh truyền nhiễm mới nổi, có thể ảnh hưởng đến nhiều cơ quan và bộ phận cơ thể.
Cảnh báo: Đã có trường hợp tử vong do nhiễm chủng nấm mới siêu mạnh đang hoành hành khắp toàn cầu
Điều đáng lo ngại nhất là siêu vi khuẩn nấm Candida auris này kháng với ít nhất một loại thuốc trị nấm, khiến cho bác sĩ chỉ còn lại một vài lựa chọn khi điều trị cho bệnh nhân.
Bệnh một đằng, dùng thuốc một nẻo
Tổn thương trên da do vi nấm và do virut Herpes hoàn toàn khác nhau nhưng vẫn có trường hợp bị nhầm lẫn dẫn đến việc dùng thuốc điều trị không đúng bệnh...